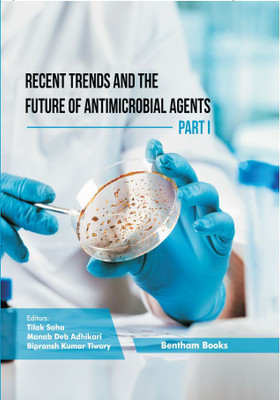
Nanopharmacology and Nanotoxicology: Clinical Implications and Methods(Hardcover, Elham Ahmadian, Magali Cucchiarini, Aziz Eftekhari)

Nanopharmacology and Nanotoxicology: Clinical Implications and Methods(Hardcover, Elham Ahmadian, Magali Cucchiarini, Aziz Eftekhari)
- Elham Ahmadian, Magali Cucchiarini, Aziz Eftekhari
Paperback & Hardcover deals ―
Amazon IndiaGOFlipkart ₹ 7231SnapdealGOSapnaOnlineGOJain Book AgencyGOBooks WagonGOBook ChorGOCrosswordGODC BooksGOe-book & Audiobook deals ―
Amazon India GOGoogle Play Books GOAudible GO* Price may vary from time to time.
* GO = We're not able to fetch the price (please check manually visiting the website).
Know about the book -
Nanopharmacology and Nanotoxicology: Clinical Implications and Methods(Hardcover, Elham Ahmadian, Magali Cucchiarini, Aziz Eftekhari) is written by Elham Ahmadian, Magali Cucchiarini, Aziz Eftekhari and published by Bentham Science. It's available with International Standard Book Number or ISBN identification 9815079700 (ISBN 10) and 9789815079708 (ISBN 13).
Nanopharmacology and Nanotoxicology: Clinical Implications and Methods
